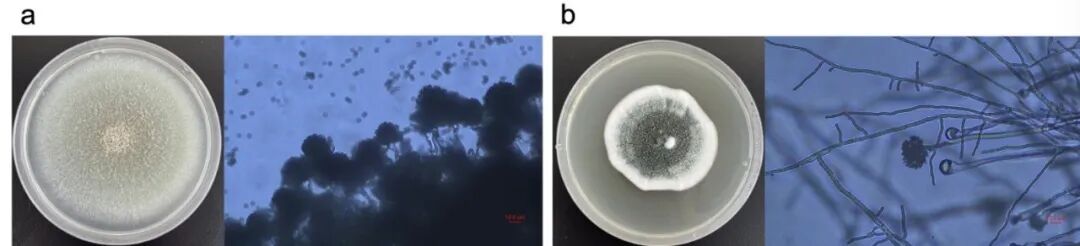
图片
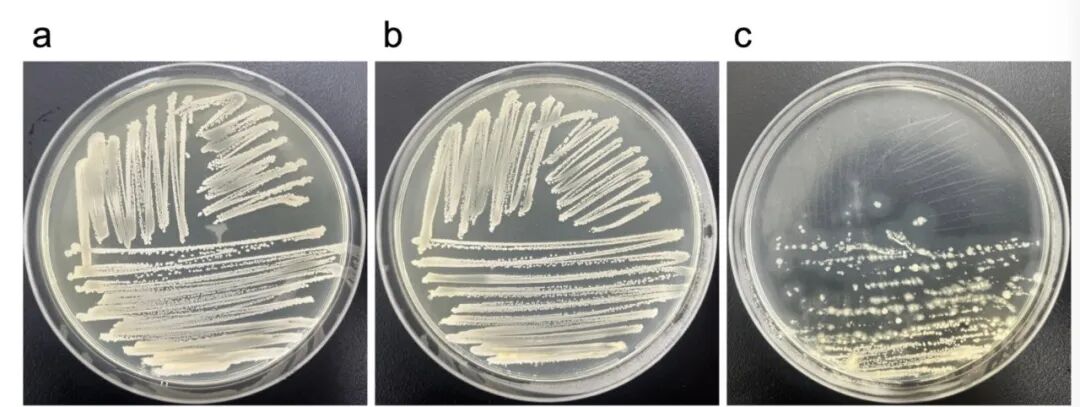
图片
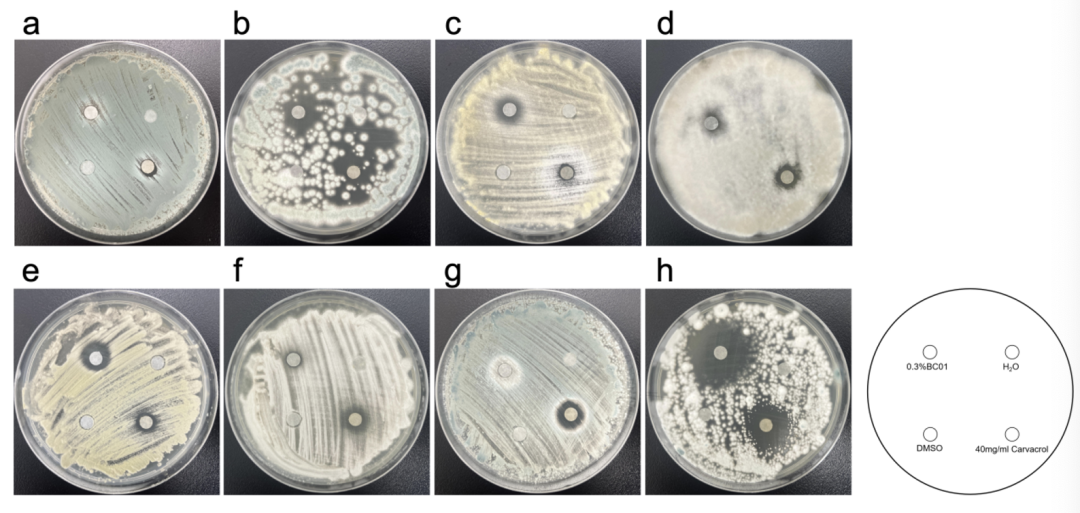
图片
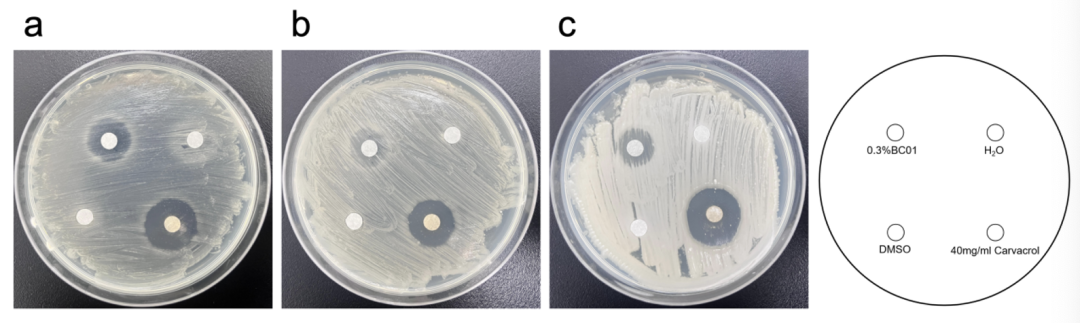
图片

一、研究背景
皮影戏作为融合中国古代工艺与传统戏曲的独特艺术形式,其表演载体皮影主要使用优质牛皮或驴皮制作,经过刮磨、晾晒、雕刻、上色等数十道工序精制而成。这些皮影文物承载着丰富的历史文化价值,但长期保存过程中面临着一定的微生物降解问题。位于四川成都的中国皮影博物馆收藏了超过20万件来自全国各地的皮影文物,时间跨度从明清至现代,是世界上最重要的皮影文物收藏机构之一。馆藏皮影文物的常见病害包括断裂、裂纹、皱褶、虫害及微生物侵蚀等。其中微生物因其分布广泛、繁殖迅速的特点,成为威胁皮影保存的主要因素。微生物可通过空气、文物运输及保存环境中的温湿度变化等因素侵蚀文物,导致皮影表面污染、其胶原蛋白降解和物理结构破坏。针对这一问题,本研究对成都中国皮影博物馆的展厅、展柜和库房三种保存环境进行了系统的空气微生物采样分析,鉴定主要致害微生物种类,并测试了两种抗菌剂的抑制效果,为皮影文物的科学保护提供了重要依据。该研究成果已发表于《npj Heritage Science》2025年第13期。
二、研究方法
本研究在成都中国皮影博物馆的展厅、展柜和库房三个典型保存环境中进行了系统的空气微生物采样与分析。采样工作于2023年3月16日至17日进行,覆盖了不同功能区域的空气微生物分布特征。在展厅环境中,研究团队选取了总面积890平方米的一号展厅作为采样区域,该展厅全年温度控制在18-26℃,相对湿度维持在45-65%。采样点分布在展厅的东北、东南、西北、西南和中心五个位置,以全面反映展厅内微生物的空间分布特征。同时,针对直接存放皮影文物的展柜环境,研究选取了四个展示柜进行封闭空间内的空气采样。此外,在长期存放皮影文物的库房环境中,采样点同样设置在中心、西北、东南、西南和东北五个代表性位置。采样过程中使用TH101B温湿度测量仪实时监测各采样点的温湿度参数,确保环境数据的准确性。
微生物采样采用基于安德森原理的Zr-2050空气采样器,该设备以10.8 m/s的冲击速度可有效捕获直径大于1 μm的颗粒物。采样时以100 L/min的流量持续采集2分钟,空气通过多孔采样头被引导至90 mm的琼脂平板上。对于细菌培养采用LB培养基(含胰蛋白胨10.0 g、酵母提取物5.0 g、氯化钠10.0 g、琼脂20.0 g,pH调至7.2),真菌培养采用PDA培养基(含马铃薯200.0 g、葡萄糖20.0 g、琼脂20.0 g)。每个采样点重复采样三次,分别暴露LB和PDA平板,细菌平板在37℃培养2天,真菌平板在28℃培养3天。
在分子生物学分析方面,研究采用十六烷基三甲基溴化铵(CTAB)法提取培养微生物的DNA。细菌鉴定通过扩增16S rRNA基因(引物341F/907R),真菌鉴定通过扩增ITS区域(引物ITS1/ITS4)。PCR产物经1%琼脂糖凝胶电泳检测后送至GENEWIZ(北京)进行测序,获得的序列通过NCBI BLAST程序与GenBank数据库中的已知分类单元进行比对。所有获得的序列已存入NCBI GenBank(细菌登录号PV650668-PV650686,真菌登录号PV652786-PV652821)。为确定优势微生物的胶原蛋白降解能力,研究配制了以骨明胶为唯一氮源的专用培养基(含骨明胶20 g、葡萄糖5 g、氯化钠0.1 g、磷酸二氢钾0.2 g、琼脂20 g,pH 7.2-7.5),将分离的菌株接种培养后观察其生长情况。抗菌实验测试了0.3%异噻唑啉酮(BC01)和40 mg/ml香芹酚对主要致害微生物的抑制效果,通过滤纸片扩散法评估抑菌圈大小,为皮影文物的微生物防治提供了科学依据。
三、结果分析与讨论
1.展厅空气微生物群落组成和菌浓分析
在展厅环境中,研究共鉴定出7种细菌和13种真菌,呈现出丰富的微生物多样性。细菌群落以枯草芽孢杆菌(Bacillus subtilis)为主导,占比高达62.86%,其次为葡萄球菌(Staphylococcus,22.86%)和大肠杆菌(Escherichia coli,14.29%)。真菌群落则以枝孢菌(Cladosporium,40.74%)和篮状菌(Talaromyces,29.63%)为优势菌属,其中尖孢枝孢菌(Cladosporium oxysporum)在多个采样点均有检出。从空间分布来看,展厅西北区域靠近入口处微生物浓度最高,细菌浓度达200 CFU/m³,真菌浓度140 CFU/m³,这与参观人流密集密切相关。整体而言,展厅平均细菌浓度为88 CFU/m³,真菌130 CFU/m³,虽符合国家室内空气质量标准,但部分区域的微生物负荷仍需关注。
表1 展厅空气环境中分离菌株的分子鉴定结果


图1 展厅空气环境中分离的4种优势真菌菌落及显微形态特征
(a)Cladosporium oxysporum; (b) Talaromyces marneffei; (c) Aspergillus ochraceus; (d) Alternaria alternata; (标尺为10μm,放大倍数×400)
图2 展厅空气环境中细菌(a)和真菌(b)群落组成
2.展柜空气微生物群落组成和菌浓度分析
展柜作为相对封闭的微环境,其微生物组成与展厅呈现明显差异。研究在四个展柜中鉴定出6种细菌和17种真菌,细菌以葡萄球菌(Staphylococcus,47.06%)为主,其次是芽孢杆菌(Bacillus)和赖氨酸芽孢杆菌(Lysinibacillus),各占23.53%。真菌群落中,曲霉(Aspergillus,48.48%)占据绝对优势,其次是青霉(Penicillium,21.21%)和篮状菌(15.15%),其中黄曲霉(Aspergillus flavus)和棒状青霉(Penicillium corylophilum)在多个展柜中被检出。值得注意的是,展柜内真菌平均浓度(192.5 CFU/m³)显著高于展厅,而细菌平均浓度(47.5 CFU/m³)则相对较低,这种差异可能与展柜密闭性导致的微环境特征有关,特别是湿度的局部变化为真菌繁殖创造了有利条件。
表2 四个展柜空气环境中分离菌株的分子鉴定结果


图3 四个展柜空气环境中分离的2种优势真菌菌落及显微形态特征
(a)Aspergillus flavus; (b) Penicillium corylophilum;(标尺为10μm,放大倍数×400)
图4 展柜空气环境中细菌(a)和真菌(b)群落组成
3.库房空气微生物群落组成和菌浓度分析
库房环境表现出更为独特的微生物特征。研究鉴定出6种细菌和6种真菌,细菌群落中大肠杆菌(47.06%)占主导地位,芽孢杆菌和赖氨酸芽孢杆菌各占23.53%。真菌群落则呈现高度单一化特征,仅检出青霉(55.56%)和曲霉(44.44%)两个属,其中烟曲霉(Aspergillus fumigatus)和杂色曲霉(Aspergillus versicolor)为主要菌种。从浓度水平来看,库房微生物负荷整体较低,平均真菌浓度98CFU/m³,细菌32CFU/m³,这得益于库房严格的环境控制和有限的人员活动。特别值得关注的是,库房东南区域未检出细菌,而其他区域的微生物分布也较为均匀,反映出库房环境管理的有效性。
表3 博物馆库房空气环境中分离菌株的分子鉴定结果

图5 博物馆库房空气环境中分离的2种优势真菌菌落及显微形态特征
(a)Aspergillus fumigatus; (b) Aspergillus versicolor;(标尺为10μm,放大倍数×400)
图6 库房空气环境中细菌(a)和真菌(b)群落组成
4.展厅、展柜和库房空气微生物群落组成相关性分析
通过比较三个环境的微生物群落,发现虽然各环境具有独特的菌群结构,但仍存在一些共有的核心微生物。细菌中的枯草芽孢杆菌、葡萄球菌和大肠杆菌在三个环境中均有分布,而真菌中的曲霉和青霉也表现出跨环境的适应性。空间分布分析显示,展厅西北区域与展柜3、展柜4在细菌组成上具有相似性,可能通过空气流通或人员接触形成了微生物交换。相比之下,真菌群落的环境特异性更强,枝孢菌主要富集于展厅,而曲霉和青霉则在展柜和库房中占优。这种分布模式暗示不同功能区域可能需要差异化的微生物防控策略。
图7 展厅、展柜和库房空气环境中真菌(a)和细菌(b)的相对丰度
(EH: Exhibition hall, SC: Show case, WH: Warehouse)
5.主要病害微生物胶原蛋白降解能力分析
研究选取8种优势真菌和3种优势细菌进行胶原蛋白降解能力测试。所有测试菌株均能在以骨明胶为唯一氮源的培养基上生长,证实其具有降解皮影主要成分的能力。其中,黄曲霉、烟曲霉和棒状青霉的生长最为旺盛,显示这些菌种对胶原蛋白具有强分解潜力。细菌测试中,枯草芽孢杆菌和地衣芽孢杆菌(Bacillus licheniformis)表现出显著的蛋白水解活性。这些发现从生理生化层面解释了微生物导致皮影生物劣化的机制,为针对性保护措施的制定提供了理论依据。

图8 真菌在骨明胶培养基上28°C培养3天后的生长情况
(a)Cladosporium oxysporum; (b) Talaromyces marneffei; (c)Aspergillus ochraceus;
(d) Alternaria alternata; (e)Aspergillus flavus; (f)Penicillium corylophilum;
(g) Aspergillus fumigatus; (h) Aspergillus versicolor
图9 细菌在骨明胶培养基上37°C培养3天后的生长情况
(a)Bacillus subtilis; (b) Staphylococcus aureus; (c) Bacillus licheniformis
6.抑菌剂对主要病害微生物抑制效果分析
抑菌实验结果显示,0.3%异噻唑啉酮(BC01)和40 mg/ml香芹酚对主要致害微生物均表现出抑制效果,但作用谱存在差异。BC01对赭曲霉(Aspergillus ochraceus)、黄曲霉和杂色曲霉的抑制率超过90%,而香芹酚对马尔尼菲篮状菌(Talaromyces marneffei)、棒状青霉和烟曲霉的抑制效果更为显著。值得注意的是,两种抗菌剂对尖孢枝孢菌和链格孢(Alternaria alternata)的抑制效果相对有限。在细菌抑制方面,香芹酚对测试的三种细菌均表现出良好效果,而BC01的抗菌谱相对较窄。这些结果为不同环境条件下抗菌剂的选择应用提供了重要参考。
图10 生物杀菌剂在PDA平板上28°C培养3天对真菌生长的抑制效果
(a)Cladosporium oxysporum; (b) Talaromyces marneffei; (c)Aspergillus ochraceus;
(d) Alternaria alternata; (e) Aspergillus flavus; (f) Penicillium corylophilum;
(g)Aspergillus fumigatus; (h) Aspergillus versicolor
图11 生物杀菌剂在LB平板上37°C培养24小时对细菌生长的抑制效果
(a)Bacillus subtilis; (b) Staphylococcus aureus;(c) Bacillus licheniformis
本研究通过对成都中国皮影博物馆展厅、展柜及库房环境的系统性微生物分析,揭示了皮影文物保存环境中潜在的生物侵蚀风险。研究发现,不同功能区域的微生物群落结构呈现显著差异:展厅因人员流动频繁而细菌丰度较高,优势菌为枯草芽孢杆菌和葡萄球菌;相对封闭的展柜和库房则更利于真菌滋生,尤其是曲霉和青霉等具有强降解能力的菌属。这些微生物在骨明胶培养基上的成功培养证实了其降解皮影胶原蛋白的潜在威胁,这一发现为理解皮影文物的生物劣化机制提供了关键证据。在防治策略方面,0.3%异噻唑啉酮(BC01)和40 mg/ml香芹酚对主要致害微生物表现出选择性抑制效果,其中BC01对曲霉属真菌效果显著,而香芹酚对篮状菌和细菌的抑制作用更为突出,这为开发针对性保护方案奠定了实验基础。
四、结语
本研究的价值不仅在于首次建立了皮影保存环境的微生物数据库,更在于为文化遗产保护提供了科学化的管理范式。研究结果表明,优化环境控制参数(如将湿度控制在45-65%)、采用高效空气过滤系统、合理选择抗菌剂等综合措施,可有效降低微生物对皮影文物的侵蚀风险。值得注意的是,展厅入口处微生物浓度显著高于其他区域的现象,提示观众流量管理在文物保护中的重要性。未来研究需进一步评估抗菌材料与文物本体的相容性,并探索微生物群落动态变化与皮质文物劣化的定量关系。这些成果不仅适用于皮影类文物,其研究框架和方法学创新也可推广至其他有机质文化遗产的保护实践,为延续文物生命、传承文化遗产提供了重要的科学技术支撑。